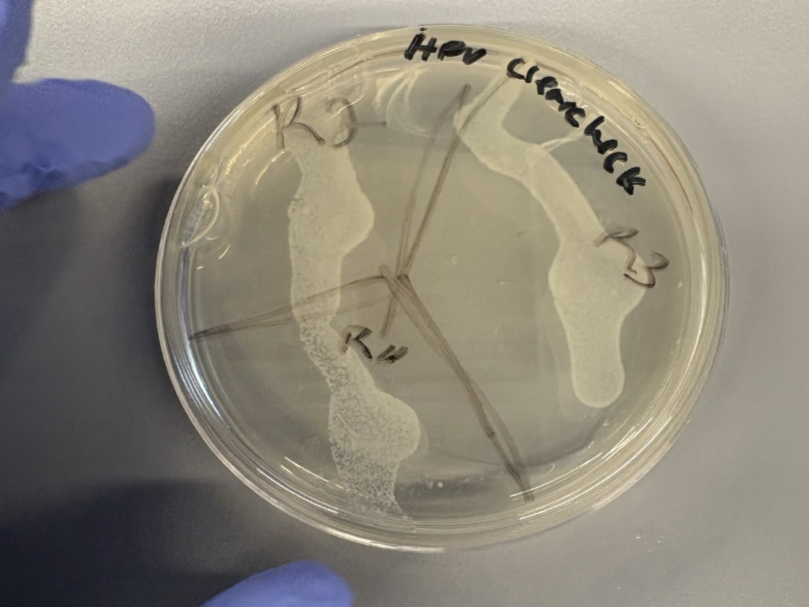
Bacterial testing to validate swab collection functionality.

HPV ClearCheck
Affordable at-Home HPV Test Kit for Men
Accessible HPV Treatment
As the design and development lead for HPV ClearCheck, I set out to address a gap my team realized during the Biomedical Engineering Scholars program. Time in Tuskegee, Alabama revealed how limited clinic access, low screening rates, and stigma were driving some of the nation’s highest HPV‑related cancer rates, especially among men who rarely receive screening. That insight shaped my goal: to create an accessible, accurate, and discreet at‑home HPV test.
I led the research, design, and evaluation of the device, validating detection methods and ensuring alignment with clinical and public‑health needs. Breaking away from the typical clinical focus, I prioritized simplicity and intuitive use; and through iterative design and continuous user feedback, I developed a comprehensive triple‑site test that anyone could use confidently at home.
Together, the team assembled a comprehensive HPV treatment, including swabs, collection tubes, transport media, educational pamphlets, and information detailing outcomes. The goal was simple: make HPV testing universally accessible.
Highlights:
400+ Surveys & Interviews
40+ Prototypes Built
3 Site Sample Collection
Discreet & Affordable Testing
Intuitive Design
Partners: Tuskegee University
Role: Design & Development Lead
Timeline: Sept. 2024 - May. 2025
The Challenge
HPV‑related cancer rates in Tuskegee, Alabama are amongst the highest in the country, driven by limited clinic access, low screening rates, and longstanding distrust rooted in the Tuskegee Syphilis Study. These barriers make early detection especially difficult.
As we mapped the problem, a critical technical requirement emerged. Effective HPV testing for men must capture oral, penile, and anal samples to cover all major HPV‑presenting sites.

During our visit, the Team met with the Mayor of Tuskegee.
With the constraints defined, I moved into prototyping. Using female HPV tests and existing anal swabs as references, I produced a wide range of early concepts that varied in geometry, materials, and bristle configurations. Each prototype was evaluated for feasibility, usability, and manufacturability.

Early-stage swab and container prototypes. Over the course of the project, I designed 40+ variations.
User testing drove the design forward. Feedback on comfort, handling, and confidence refined each iteration, ultimately converging on a swab with an injection‑molded core and electrostatically flocked nylon bristles. A small protrusion below the tip guides insertion depth, and a paired transport tube supports safe handling. The final design delivered reliable cellular pickup while remaining simple, comfortable, and scalable for broad deployment.

Final swab design. Nylon bristles are electrostatically flocked onto the solid plastic core.
The Solution
The test kit was designed to support users beyond sample collection. While I developed the physical components, my team built the educational and aftercare systems to remove ambiguity throughout the process.
The workflow is straightforward: users collect their samples, mail them to a lab, and receive results with structured next‑step guidance. For positive results, the kit provides clear, actionable instructions so no one is left navigating a diagnosis alone.
Collected epithelial cells maintained stable morphology over several days, confirming reliable preservation.
Community engagement shaped the next phase. We returned to Tuskegee University for the “Wipe Out Cervical Cancer” campaign, where we presented the final kit, gathered feedback, and formed a partnership with Vax2Stop Cancer. One speaker captured the importance of male testing with a line that stayed with me: “my son can save your daughter.”
Adoption data clarified the final constraint. In a survey of 155 participants, every individual was willing to use the kit, but cost was decisive: 67.4% would only use it if priced under $25. Because the device was engineered for scalable production, fabrication costs of $8.25–$15.55 per kit make widespread access both feasible and practical for the communities most affected.

My team held many feedback sessions, allowing the community to guide the design of the kit.

Contents of the completed test kit.